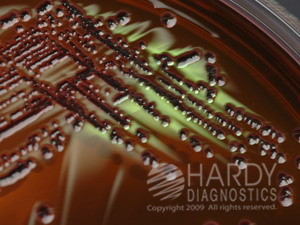
EMB Levine Agar (Eosin Methylene Blue)

Details
- Manufacturer: Hardy
- Mfr. Cat. # G25
- Brand Name: Hardy
Microbiology » Culture Media Plates
EMB Levine Agar (Eosin Methylene Blue)
Medix Item Code: HEL-0G25
$14.50 per Pack
List Price: $16.95
You Save: $2.45 (14%)
Size: 10 per pk.
Special shipping requirements
- Refrigerated - This item is refrigerated and must ship by air with ice.
Features
- (Eosin Methylene Blue Agar, Levine) For isolation and differentiation of gram negative bacilli.
Description
EMB Levine Agar (Eosin Methylene Blue), 15x100mm plate, by Hardy Diagnostics, For isolation and differentiation of gram negative bacilli. refrigerate on arrival. EMB Agar formulations are recommended for use as selective and differential media for the isolation of gram negative bacilli (including coliform organisms and enteric pathogens) from clinical and nonclinical specimens. Lactose fermenting gram negative colonies will have dark centers. Non lactose fermentors will be pink or colorless. Some strains of E. coli, but not all, will produce a "green sheen" on this medium. Most Candida spp will grow on EMB.